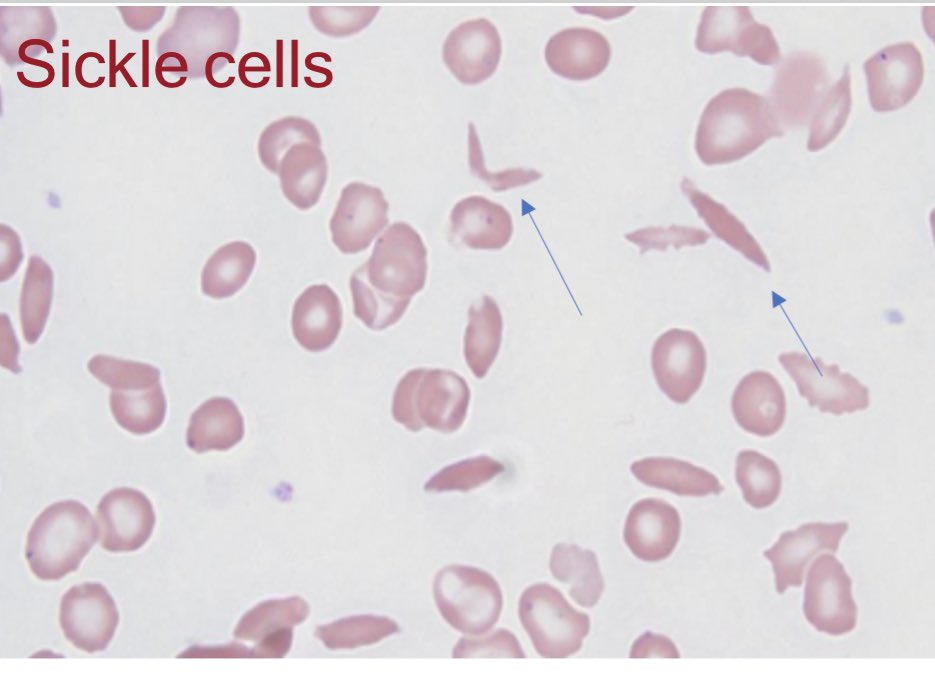

#sicklecellAwarnessmonth
#منجلية
#دم
#مختبرات_طبية
شهر سبتمبر يمثل شهر التوعية بمرض الأنيميا المنجلية،
وهذا ثريد عن sickle cell anaemia
#منجلية
#دم
#مختبرات_طبية
شهر سبتمبر يمثل شهر التوعية بمرض الأنيميا المنجلية،
وهذا ثريد عن sickle cell anaemia
السبب
وراثة sickle Beta -globin gene
يتكون الجين لما يحدث اختلال في beta-globin gene بتكون ال valine بدلاً لل glutamic acid
وراثة sickle Beta -globin gene
يتكون الجين لما يحدث اختلال في beta-globin gene بتكون ال valine بدلاً لل glutamic acid
٢- sickle cell trait
وهو لما يكون Heterozygous sickle cell (Hb S)
طبعاً تكون شكل الخلايا طبيعي بسبب ان نسبة الهيموغلوبين S اقل من ٤٥٪
ويجب الاهتمام بالمريض/ة وقت الحمل ، في المرتفعات ، مع التخدير ،
ليش؟
وهو لما يكون Heterozygous sickle cell (Hb S)
طبعاً تكون شكل الخلايا طبيعي بسبب ان نسبة الهيموغلوبين S اقل من ٤٥٪
ويجب الاهتمام بالمريض/ة وقت الحمل ، في المرتفعات ، مع التخدير ،
ليش؟
الاختبار الثاني هو solubility test
مبدا عمل الاختبار هو كالتالي
عند اضافة مادة dithionate وهي مادة كيميائية تسبب تكسر خلايا الدم الحمراء وبالتالي تحرر الهيموغلوبين .
اذا كان الهيموغلوبين Hb S فسوف يكون غير ذائب اي سوف ينتج عنه turbidity وبالتالي يكون غير شفاف
مبدا عمل الاختبار هو كالتالي
عند اضافة مادة dithionate وهي مادة كيميائية تسبب تكسر خلايا الدم الحمراء وبالتالي تحرر الهيموغلوبين .
اذا كان الهيموغلوبين Hb S فسوف يكون غير ذائب اي سوف ينتج عنه turbidity وبالتالي يكون غير شفاف
في السعودية
4.2% حاملين للمرض
0.26 % مصابين بالمرض
المنطقة الشرقية تحتل النسبة الأكبر بين المناطق
المصدر
moh.gov.sa
4.2% حاملين للمرض
0.26 % مصابين بالمرض
المنطقة الشرقية تحتل النسبة الأكبر بين المناطق
المصدر
moh.gov.sa
جاري تحميل الاقتراحات...